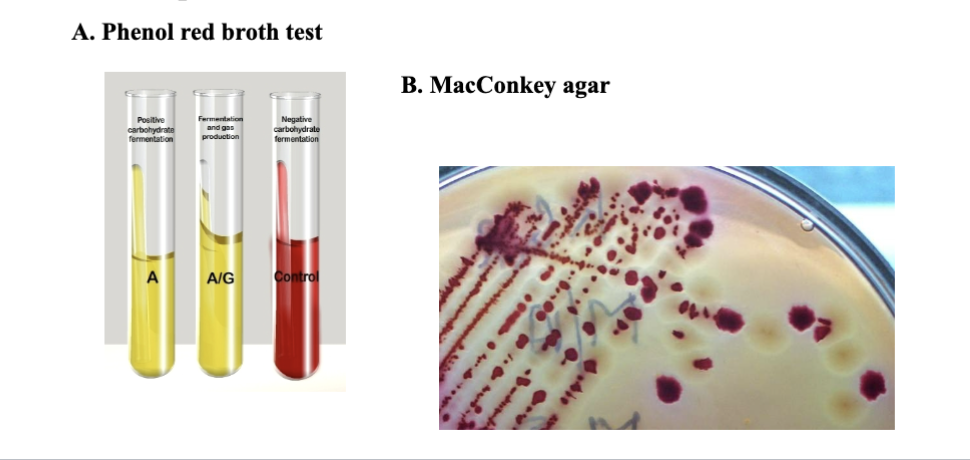
<p>to quickly identify the microbe causing the disease and prescribe an effective antibiotic, hospitals use rapid and inexpensive biochemical tests, like the phenol red broth test and MacConkey agar. Researchers use fermentation as a tool to create a metabolic fingerprint based on what an organism can and can’t ferment. </p>

MICROBIO UNIT 4
1/105
There's no tags or description
Looks like no tags are added yet.
Name | Mastery | Learn | Test | Matching | Spaced | Call with Kai |
|---|
No analytics yet
Send a link to your students to track their progress
106 Terms
biochemically, what does all life require?
water (universal solvent)
carbon and other nutrients (carbon foundation of all 4 macromolecules)
free energy (G): energy available to do work
reducing power: source of electrons
define energy
the ability to do work
what is the most common type of energy used in living systems?
chemical energy stored within bonds of ATP
what is G, ΔG, and ΔG°?
G measures the maximum amount of free energy released. G = H-TS
ΔG = Gfinal - Ginitial = ΔH - TΔS when ΔH is enthalpy and ΔS is entropy.
ΔG° is Gibbs free energy under standard conditions
what is the difference between an exergonic and endergonic reaction?
An exergonic reaction releases energy, and endergonic reaction absorbs energy.
ΔG < 0 indicates what kind of reaction?
exergonic reaction that is spontaneous
ΔG > 0 indicates what kind of reaction?
endergonic reaction (nonspontaneous - requires energy input)
Are biological reactions at standard conditions in vivo?
in vivo means in a living cell. Biological reactions are not at standard conditions in vivo, but use coupling to function
How do researchers calculate ΔG?
ΔG = ΔH - TΔS when H is enthalpy (heat energy) and S is entropy (disorder)
what factors determine the ΔG of a reaction?
intrinsic properties of rxn (chemicals involved)
concentrations of reactants and products
environmental factors (temp, pressure, ionic strength)
how does growth or anabolism effect entropy?
anabolism is growth, building complex molecules from simpler ones. Anabolism DECREASES entropy. endergonic reactions.
are reactions that decrease entropy endergonic or exergonic?
endergonic
What provides the energy for most anabolic rxns on earth?
ATP hydrolysis provides direct energy source: (ATP —> ADP + Pi). releases energy that is coupled to the biosynthetic pathways.
Indirectly, the sun drives production of ATP for photosynthesis, and chemical bonds in inorganic molecules for chemosynthesis.
Catabolic reactions tend to be endergonic/exergonic ?
exergonic
to build a live cell, you need:
energy, carbon, electrons
diagram of the relationships between food molecules, cell components, waste products, simple precursors:

phototrophs obtain energy from ___
light
what are the two kinds of photosynthesis that phototrophs utilize?
oxygenic (O2 produced) and anoxygenic (no O2 produced)
chemotrophs obtain energy from ___
chemical reactions
what is the electron acceptor for aerobic reactions?
O2
what is the electron acceptor for anaerobic respiration?
anything other than O2
diagram comparing chemotrophy and phototrophy

what is the energy source for chemoorganotrophs?
organic molecules
what is the energy source for chemolithotrophs?
inorganic molecules
what is the carbon source for an autotroph?
CO2
what is the carbon source for a heterotroph?
organic molecules
what is the electron source for an organotroph?
organic molecules
what is the electron source for a lithotroph?
inorganic molecules
diagram comparing energy, carbon, and electron sources for macromolecule formation

cells need ______ to make chemical bonds
reducing power
what is reducing power?
ability to donate electrons during redox reactions
what do redox reactions consist of?
two half reactions:
electron donor: transfers electrons (oxidized)
electron acceptor accepts electrons (reduced)
why is regulation of metabolic pathways so important?
to conserve resources and respond to environmental changes
what are 3 specific methods microbes use to regulate metabolic processes?
Compartmentalization of processes in space or time
Regulation of synthesis of a particular enzyme
Post-translational modification of key enzymes
the phosphorylation or dephosphorylation is an example of what type of metabolic control?
a type of post-translational modification
what type of control is the lactose operon?
regulation of synthesis of a particular enzyme (positive or negative control)
how do enzymes speed up chemical reactions?
by lowering Ea (energy of activation)
where do enzymes bind their substrates?
in their active sites
diagram showing effect of enzyme on activation energy
exergonic reaction bc products have lower free energy than substrates.
substrates (A+B) —> Products (C+D)

do enzymes get changed by the reactions that they catalyze?
No, they do not get permanently changed or consumed by the rxns they catalyze. They are theoretically reversible.
how are endergonic reactions accomplished in vivo?
coupling is used between endergonic and exergonic reactions, so overall rxn has negative or zero free energy change.
how does altering pH, substrate concentration, or temperature have on most enzymes?
altering pH and temperature exemplify a bell-shaped curve. high heat can denature enzymes irreversibly.
enzymes have optimal pH based on environment
increasing substrate concentration follows a saturation curve. increasing substrate concentration increases reaction rate until Vmax is reached.
these changes affect an enzyme’s conformation or the frequency of collisions with substrates.

Does the action of enzymes in glycolysis alter the energy harvested from oxidation of glucose to form carbon dioxide?
No, enzymes do not change the energy level. Enzymes mediate glycolysis in vivo, but don’t change the energy yield.

if oxygen is an electron acceptor, is it oxidized or reduced?
reduced
what is Eo?
standard reduction potential - it indicates how well a compound ACCEPTS electrons (potential to be REDUCED)
what does a negative Eo (reduction potential) indicate about a reaction?
it indicates a low potential for reduction, and a high potential for oxidation.
what does a positive Eo indicate?
high potential for reduction, low potential for oxidaiton
the greater the difference in Eo from donor to acceptor, the __lesser/greater__ the energy yield
GREATER
What compounds have greater energy, reduced compounds or oxidized compounds?
reduced compounds
If glucose was oxidized and nitrate reduced, which molecule is the electron donor? which is the electron acceptor?
electron donor: glucose
electron acceptor: nitrate
Compare and contrast NAD+/NADH in the ETC
NAD+ is reduced, NADH is oxidized. These coupled reactions function as electron carriers and fuel ATP production.
what are the 3 forms of energy storage in a cell?
glycogen (long term energy storage)
ATP (immediate energy currency)
NADH (high energy electron carrier)
why does a cell have 3 forms of energy storage?
to store different types of energy
what are the 3 common mechanisms by which ATP is generated?
substrate level phosphorylation: energy-rich substrate bond hydrolyzed directly to drive ATP formation
oxidative phosphorylation: movement of e- generates PMF used to make ATP
photophosphorylation: light used to form PMF
diagram showing relationship betwen food molecules and waste products

why do cells contain relatively large amounts of electron donors (e.g. glucose) and terminal electron acceptors (e.g. oxygen), but only have NAD+/NADH in relatively small concentrations?
glucose and oxygen are consumed and transformed, but NAD+ and NADH are recycled continuously and function as temporary electron shuttles.
explain the set- up of the electron tower? Can succinate donate electrons to NAD+
electron tower organizes compounds based on their Eo , going from least (high oxidation potential, electron donor) to greatest (high reduction potential, electron acceptor) values. electrons can only spontaneously fall down the electron tower. electrons must flow from a more negative potential to a more positive one. in the tower, oxidized forms are on left, reduced forms on right.

what is the Embden Myerhof Parnas pathway?
(another name for glycolyis). the nearly universal pathway for glucose catabolism that oxidizes glucose to pyruvate.
what are the multiple forms of catabolism that glycolysis can participate in?
fermentation, aerobic respiration, anaerobic respiration
what are the three pathways that convert glucose to pyruvate?
Glycolysis
Entner-Doudoroff (ED)
Pentose Phosphate Pathway (PPP)

what are the 3 stages of central metabolism in heterotrophs?
Glycolysis
embden-meyerhof-parnas (glycolysis)
pentose phosphate
entner douderoff
TCA cycle - pyruvate to CO2
Electron transport chain - requires membrane, PMF, and oxidative phosphorylation
How does substrate-level phosphorylation differ from oxidative phosphorylation?
substrate phosphorylation: a direct transfer of a phosphate group from a substrate to ADP to form ATP
oxidative phosphorylation: indirect transfer from oxidation of high energy electron carriers and uses the PMF to fuel ATP synthase
what type of phosphorylation is used in the Embden Myerhof Parnas (glycolysis) pathway?
substrate phosphorylation during stage II
what kind of organisms use the Entner Douderoff pathway?
mostly bacteria (gram negative) and many gut microbes. Quicker pathway to pyruvate.
which pathway provides sugars for nucleotide synthesis?
the pentose phosphate pathway.
glc-6-P —> 6-phosphogluconate —> ribulose-5-P —> nucleic acid synthesis
which pathway is found in nearly every organism?
the EMP pathway (glycolysis) and the PPP are found in nearly every organism
what are the possible fates of pyruvate after being formed by the EMP?
it can enter the TCA cycle to be further oxidized to acetyl CoA (aerobic respiration)
enter fermentation for partial oxidation
utilized in gluconeogenesis (glycolysis in reverse to generate glucose for the body) and AA synthesis
facultative anaerobes vs pure fermenters
facultative anaerobes: possess genetic machinery for both aerobic respiration and fermentation
pure fermenters: completely lack ETC, but rely entirely on glycolysis followed by fermentation to generate ATP.
facultative anaerobes vs pure fermenters: ATP production
facultative anaerobes: 36-38 ATP per glc molecule
pure fermenters: 2 ATP per glc molecule
which yield more energy per glucose molecule: aerobic respiration, anaerobic respiration, or fermentation?
aerobic: 36-38 ATP
anaerobic: 2-36 ATP
fermentation: 2 ATP
how do hexokinase and phosphofructokinase regulate the rate of glycolysis
phosphofructokinase is the irreversible step of glycolysis that forms 1,6-biphosphate. It is inhibited by ATP, citrate, and FA
hexokinase is the enzyme that phosphorylates glc to glc-6-P and is the intake valve, trapping the glc in the cell.
what compounds are at high concentration when a cell needs more energy?
High ADP/AMP, high NAD+/FAD
what compounds are at high concentration when a cell has excess energy?
high ATP, high NADH/FADH2, high citrate
would a cell with excess ADP and NAD+ have active or inactive phosphofructokinase (PFK)?
it would have very active PFK, because the cell needs to run glycolysis to produce energy (ATP).
during glycolysis, where is ATP produced?
Glycolysis occurs in the cytosol. ATP is used during the first half of glycolysis, and it produced during the second half of glycolysis.
1,3-biphosphoglycerate —> 3-phosphoglycerate
at the conversion of PEP —> pyruvate
how many carbons are in glucose?
6 carbon atoms (C6H12O6)
how many carbons are in pyruvate?
3 carbons
for each glucose that enters the EMP (glycolysis) pathway, how many pyruvates are produced? How many NADH are made?
2 pyruvate
2 NADH
a typical fermentation reaction involves removing electrons from ____ that was produced from glycolysis and putting them on ____.
NADH (oxidized), pyruvate (reduced)
how is fermentation used in diagnostic microbiology?
to quickly identify the microbe causing the disease and prescribe an effective antibiotic, hospitals use rapid and inexpensive biochemical tests, like the phenol red broth test and MacConkey agar. Researchers use fermentation as a tool to create a metabolic fingerprint based on what an organism can and can’t ferment.
what is happening when phenol red turns to yellow in a test tube?
the bacteria successfully fermented the specific carbohydrate provided in the tube
which pathways does fermentation include? does fermentation require oxygen?
what does hexokinase do?
what does phosphofructokinase do?
what does pyruvate kinase do?
what does aldolase do?
point of no return enzyme
why is the pentose phosphate pathway important?
provides intermediates (like our 5C and 7C sugars) for photosynthesis and for biosynthesis of nucleotides, cell wall components, and amino acids.
if we stop with pyruvate, what process occurs?
fermentation
in fermentation, what is the electron acceptor for NADH?
pyruvate
what are the 3 functional components of the respiratory electron transport chain?
an initial substrate dehydrogenase
a set of electron carriers
a terminal oxidase
what is considered the smallest biological motor?
ATP synthase
what is ATP synthase powered by?
the PMF
why fix nitrogen?
nitrogen needed for proteins, nucleic acids, other organics
the triple bonds connecting the 2 diatomic nitrogen atoms
biosynthesis requires:
essential elements (C, N, O, other elements)
reducing power (NADPH common)
energy: ATP, PMF
most metabolic pathways are: anabolic/catabolic/amphibolic?
amphibolic
what are the advantages to amphibolic pathways?
fewer enzymes used: less energy to make these proteins, fewer genes to make these proteins
key enzymes used as control points - allows for directionality based on cell energy level
which process (glycolysis or gluconeogenesis) would be favored in a cell with low NADH and ATP, high NAD+ and ADP?
glycolysis
what processes would be favored in a cell with high NADH, low NAD+, high ATP, and low ADP?
gluconeogenesis preferred over glycolysis
if a cell is actively synthesizing amino acids, it runs the risk of
taking too much glucose out and running out of carbon intermediates to keep the CAC going